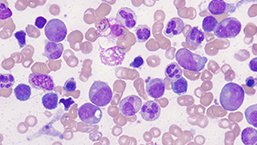
Neutropenia a MDS

Występowanie i kliniczne znaczenie neutropenii u osób, które miały rutynowo wykonaną morfologię krwi obwodowej i ocena związku neutropenii z ryzykiem rozwoju nowotworów hematologicznych m.in. zespołów mielodysplastycznych.
Materiał przeznaczony wyłącznie dla pracowników służby zdrowia
Ten materiał jest dostępny dla zarejestrowanych użytkowników.
Zaloguj się
Szanowni użytkownicy,
część materiałów udostępnianych na naszym portalu jest przeznaczona
wyłącznie dla lekarzy.
Wynika to z regulacji prawnych, do których musimy się stosować.
Jeśli nie jesteś lekarzem, zachęcamy do korzystania z przygotowanych przez nas materiałów dostępnych w zakładce dla pacjentów.







